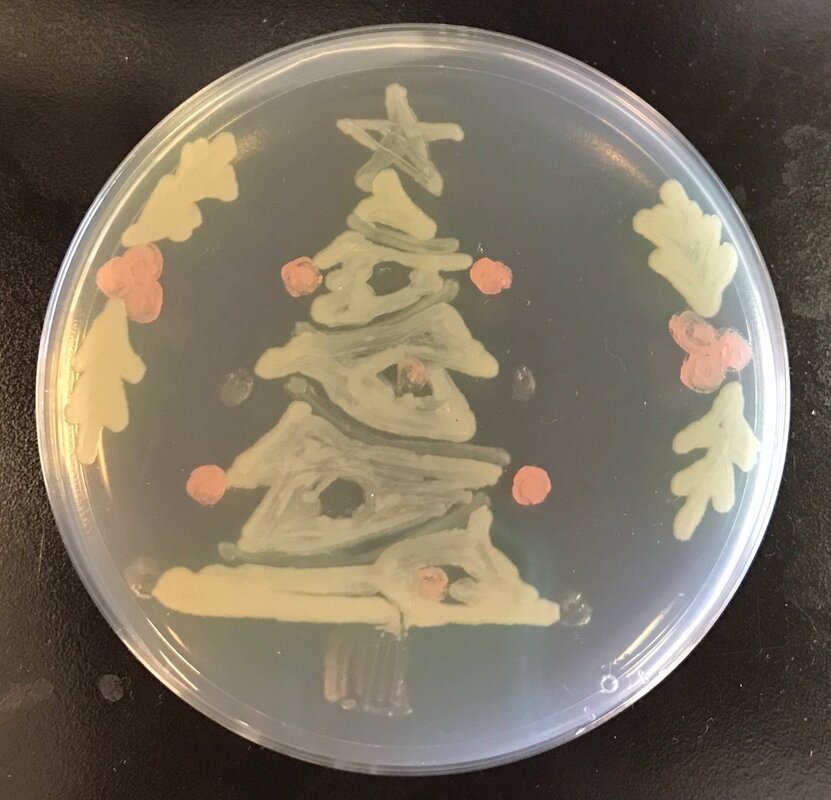

Дорогие коллеги!
Пусть в эти волшебные дни сбудутся самые заветные Ваши желания, воплотятся в жизнь самые смелые идеи, реализуются профессиональные и личные планы!
Удачи Вам, здоровья, больших успехов, открытий и мудрых решений, оптимизма в достижении намеченных целей!
Спасибо, что в уходящем году вы были с нами. До новых встреч в наступающем!